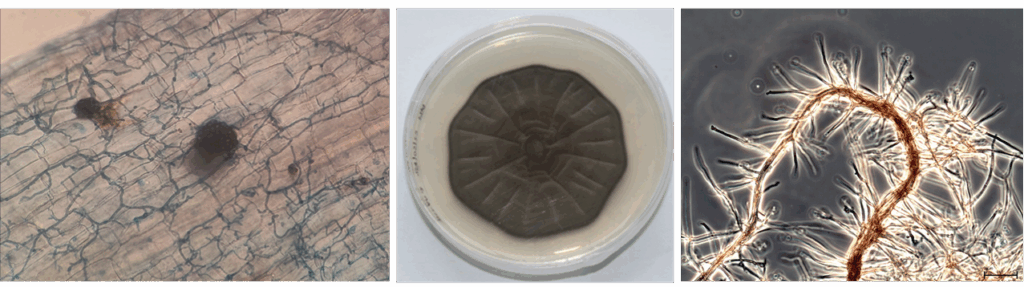

After several years without a dedicated gathering, the Black Yeasts – Chaetothyriales community is reuniting at a moment of rapid discovery and fresh challenges.
From newly resolved species complexes and cryptic lineages reshaping ecology and phylogenetics, to evolving clinical threats that press our diagnostics and antifungal strategies, to biotechnological breakthroughs in extremotolerance, bioremediation, and enzyme discovery, chaetothyrialean fungi are rewriting the script at every turn.
This workshop aims to reconnect clinicians, taxonomists, environmental microbiologists, and applied scientists to compare notes on what has changed, and what still resists explanation, since we last met. Expect state-of-the-art lectures, lively debate on persistent grey zones (species boundaries, susceptibility testing, environmental reservoirs), and concrete plans for collaborative projects that can move our field from tantalizing hints to testable, reproducible solutions. The meeting will provide a discussion-friendly environment designed to strengthen collaborations and shape future research directions in Chaetothyriales studies, hosted in the historic and architecturally remarkable setting in the heart of Barcelona.
The organizing committee invites abstracts covering novel research results on the following major topics and specific keywords:
Presentation formats:
Abstracts will undergo single-blind review by the Scientific Committee based on scientific quality, relevance, and balanced representation of topics and career stages. Abstracts will be published in the journal One Health Mycology (www.onehealthmycology.org). Authors are invited to publish their work in the journal. Data-rich papers are preferred, without length limitations. Publication is free of charge.
Relevant communications on black fungi from groups outside the Chaetothyriales will also be considered and are welcome.
We recommend staying in Ciutat Vella (Raval/Gothic Quarter) or around Plaça Catalunya / Universitat (Eixample), all within easy walking distance from the Institut d’Estudis Catalans (IEC), Carrer del Carme 47. Barcelona availability in the city centre can fill up quickly, so early booking is advised.
Nearby hotel examples (different price ranges):
